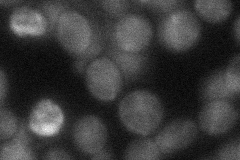
YDR075W
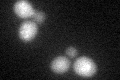
YDR075W
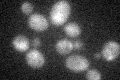
YDR075W

View description
Catalytic subunit of an evolutionarily conserved protein phosphatase complex containing Psy2p and the regulatory subunit Psy4p; required for cisplatin resistance; involved in activation of Gln3p
Localization:
Intensity:
Fold change:
Significance:
-
C’ GFP library in SD

nucleus:cytosol27.12 -
N' NOP1pr-GFP in SD

cytosol,punctate,nucleus53.8311 -
N' TEF2pr-mCherry in SD

punctate,nucleus14.0417 -
N' NATIVEpr-GFP in SD
cytosol31.5231 -
N' TEF2pr-VC and Cyto-VN in SD

below threshold23.2505 -
C’ GFP library in SD+DTT
nucleus.cytosol23.330.86No -
C’ GFP library in SD+H2O2
nucleus.cytosol30.041.1No -
C’ GFP library in Starvation Media

nucleus,cytosol20.270.74Yes -
C’ GFP library on the background of Pup2-DaMP

nucleus:cytosol -
C’ GFP library on the background of CCT mutant

nucleus:cytosol28.00341.03221No
